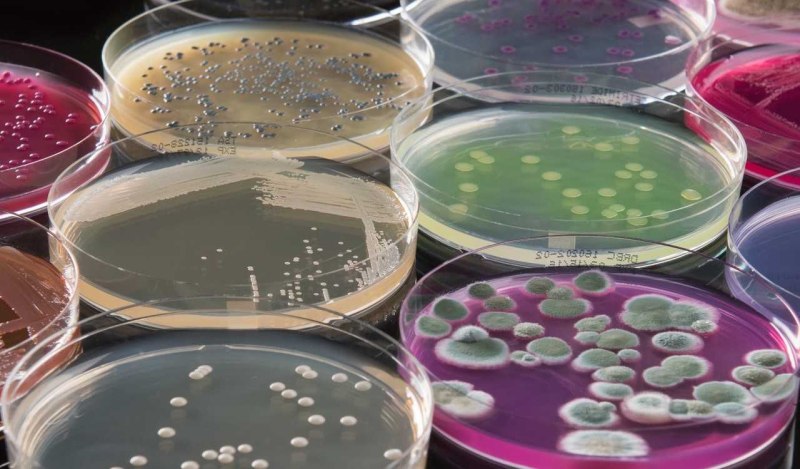

Бактерии хроококковые (72 фото)
Комментарии (0)

Цианобактерия лингбия

Бациллы под микроскопом


Вирусы и бактерии

Галофильные вибрионы

Бактерии под микроскопом

S. aureus золотистый стафилококк

Бациллы микроорганизмы

Синезелёные водоросли цианобактерии

Бактериофаг эшерихиозный

Brevibacterium ammoniagenes

Сальмонелла тифимуриум

Кокки бактерии

Цианобактерии Gloeocapsa

Escherichia coli жгутики

Формы бактериальных клеток палочки

Synechococcus elongatus

Kingdom Monera

Бациллы бактерии микробиология

Глеокапса водоросль


Одноклеточная зеленая водоросль хлорелла


Бактерии Haemophilus influenzae

Microcystis aeruginosa

Одноклеточная водоросль хлорелла

Бактерии Oceanospirillales

Вибрионы примеры бактерий

Kingdom Monera

Микроорганизмы анаэробы

Бациллы бактерии под микроскопом

Живые микроорганизмы

Форма бактерий кокки палочки извитые

Энтеробактерии под микроскопом

Бациллы, спириллы, вибрионы, кокки.

Одноклеточные планктонные водоросли
Питательные среды Оболенск

Колонии бактерий в чашке Петри

Бактерия сальмонелла

Microcystis wesenbergii

ИППП возбудитель бактерия

Arthrospira platensis

Суперинфекции рисунки

Kingdom Monera


Колонии Microcystis aeruginosa

Древние бактерии

Стрептококк Аурелия.

Кишечная палочка пиелонефрит

Зеленящий стрептококк

Бациллы форма бактерии

Микроцистис водоросль

Пиогенный стрептококк

Грамположительные кокки. Стафилококки.

Лактобациллы Бревис


Одноклеточная водоросль хлорелла

Классификация бактерий по форме микробиология

Аэробные бациллы

Энтерококки грамположительные

Бактерии под микроскопом


Кишечная палочка Escherichia coli


Micrococcus luteus микроскоп

Хлорелла и вольвокс

Коринебактерии Corynebacterium SPP.

Патогенные микробы микробиология

Цианобактерии микроцистис


Микроцистис водоросль

Читайте также

---
Красильная багрянка

---
Бактерии вибрионы (59 фото)

---
Бактерии холерный вибрион (60 фото)

---
Бактерии микрококки (69 фото)

---
Бактерии спирохеты (72 фото)

---
Бактерии носток (68 фото)

---
Бактерии золотистый стафилококк (69 фото)

---
Бактерии спироплазма (67 фото)

---
Бактерии плектридии (67 фото)

---
Бактерии планктомицеты (69 фото)

---
Бактерии метициллинрезистентный золотистый стафилококк (61 фото)